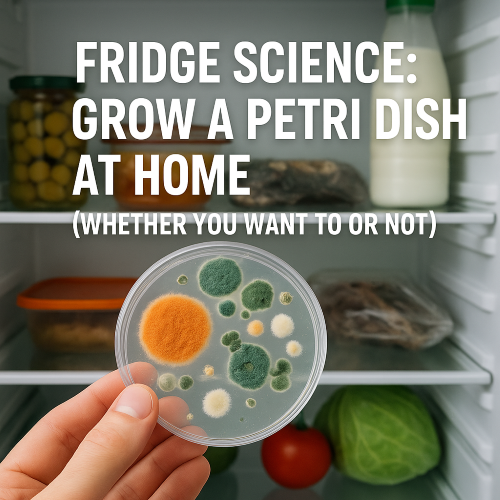

The Hidden Dangers of Leftovers, Expired Food, and Mold Museums
Ever opened your fridge and felt like you were peering into a biology experiment gone rogue? Congratulations — you’ve accidentally curated your very own mold museum.
Welcome to Fridge Science 101, where the petri dishes grow themselves, leftovers defy the laws of time, and that mysterious Tupperware in the back could probably walk out on its own if it had legs.
The Accidental Lab in Your Kitchen
Let’s get this out of the way: your refrigerator is not a cryogenic vault that halts time. It’s more like a slow cooker for bacterial ambition. Every time you forget that half-eaten lasagna, leave that bag of wilting spinach, or misplace the open yogurt, you’re offering the perfect breeding ground for fungi, bacteria, and possibly new forms of life NASA would be interested in.
Here’s what’s really growing behind your milk carton:
- Penicillium (mold): Congrats! You might be growing the same genus used to make penicillin. Unfortunately, the mold on your bread won’t cure anything—it’ll just ruin your sandwich.
- Listeria monocytogenes: Unlike many bacteria that die in the cold, Listeria thrives in your fridge. It’s the overachiever of foodborne pathogens and can cause serious illness, especially in pregnant women and the elderly.
- Clostridium botulinum: Ever stored leftover canned food directly in the can? That’s a solid strategy—for creating one of the deadliest toxins known to humankind.

Expired Food: The Ticking Time Bomb
Expiration dates are not a suggestion. They’re a warning. Ignoring them is like playing roulette with your digestive system. The bloated cheese packet, the deli meat that smells “almost fine,” and the slimy cucumbers in your crisper drawer? All auditions for the next episode of “How I Got Food Poisoning.”
Leftovers: A Love Story Gone Rotten
We all have the best intentions. “I’ll eat this tomorrow,” you say, optimistically shoving a stack of containers into the fridge. Tomorrow becomes next week, and next week becomes “what the hell is that?”
A good rule of thumb:
If you have to ask what it is, it’s probably time to throw it out.

Mold Museums: Coming to a Fridge Near You
Have you ever opened a container to find a fuzzy green ecosystem more vibrant than your houseplants? That’s your very own mold museum exhibit. Take pictures if you must, but then throw it away. This is not the kind of home science project your digestive tract wants to experience.
Also, fun fact: smelling mold spores can make you sick. So the “sniff test” is not just unreliable—it’s potentially dangerous.
How to Avoid Becoming a Biohazard Curator
- Label and date leftovers: If you can’t remember when you made it, you probably shouldn’t eat it.
- The 3–4 Day Rule: Most cooked leftovers should be eaten within this window. After that, it’s a bacterial block party.
- Don’t eat with your eyes closed: If something smells off, looks off, or has taken on a new color… it is off.
- Do a weekly fridge audit: Make it part of your weekend routine. Your stomach will thank you.
Conclusion: Clean Fridge, Clear Mind
The next time you reach for that foil-covered “mystery meat” in the back of your fridge, remember: just because it hasn’t walked out yet doesn’t mean it won’t. Respect the science of spoilage. Don’t grow a petri dish at home—unless you’re an actual microbiologist with a hazmat suit.
Because in the war between man and mold, your fridge is the battlefield. And the mold? It’s winning.
Like what you read?
Check out more darkly humorous takes on modern life at What Not to Not, where bad examples make for good advice.